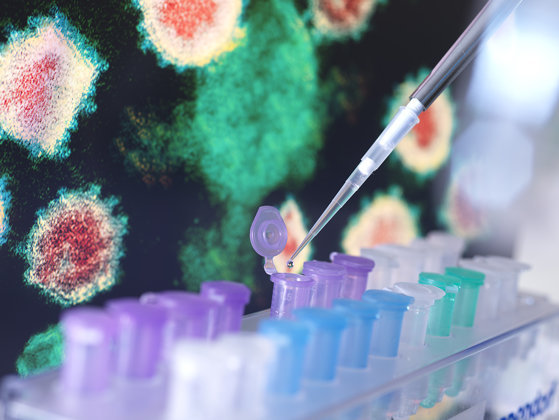

Peste 12.000 de cazuri de adenovirus au fost înregistrate în acest stat din ianuarie.
Mai mult de 3.000 de copii au fost internaţi în spital cu simptome severe asemănătoare gripei, notează The Guardian.
Medicii avertizează că numărul de decese şi de cazuri este probabil să fie mult mai mare decât statisticile oficiale.
Rapoartele presei locale estimează că numărul deceselor depăşeşte 100 de copii.
Unele spitale au declarat că secţiile de pediatrie sunt pline şi există informaţii conform cărora copiii sunt nevoiţi să împartă paturile de spital.
Adenovirusurile pot provoca infecţii respiratorii, oculare şi stomacale. Oficialii din domeniul sănătăţii spun că două tulpini mutante de adenovirus sunt responsabile pentru numărul de copii bolnavi şi morţi.
Virusul a fost descoperit şi în statele Maharashtra şi Karnataka.
Concediile angajaţilor din sănătate au fost anulate pentru a face faţă volumului mare. Clinicile trebuie să stea deschide 24 de ore pe zi, 7 zile pe săptămână. Protocoalele folosite în timpul pandemiei Covid, cum ar fi purtarea măştilor şi distanţarea socială, sunt introduse pentru a încetini infecţiile, deşi nu s-a ordonat închiderea şcolilor.
„Gravitatea epidemiei este fără precedent”, a declarat medicul pediatru Apurba Ghosh.
Pentru cele mai importante ştiri ale zilei, transmise în timp real şi prezentate echidistant, daţi LIKE paginii noastre de Facebook!
Urmărește News20 pe Instagram ca să vezi imagini spectaculoase și povești din toată lumea!
Răspunde pe site-urile Nationalul, News20, Ziarul Financiar și pe paginile noastre de social media – ȘTIU și Nationalul. Vezi răspunsul la Știu, de la ora 19.55, Nationalul.
Conținutul website-ului www.news20.ro este destinat exclusiv informării și uzului dumneavoastră personal. Este interzisă republicarea conținutului acestui site în lipsa unui acord din partea NEWS20. Pentru a obține acest acord, vă rugăm să ne contactați la adresa vanzari@news20.ro.